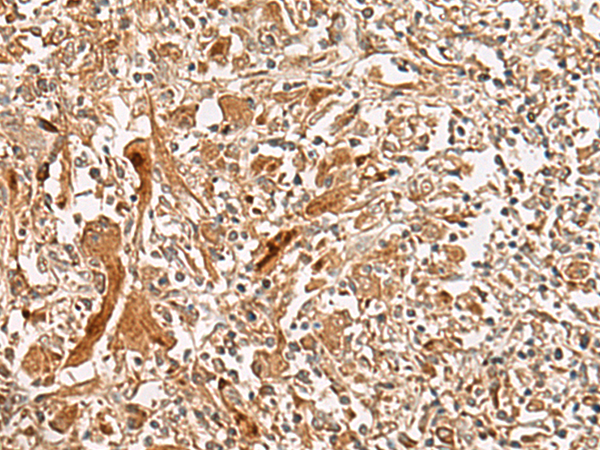

中文名稱: 兔抗GCC2多克隆抗體
抗 原: GCC2
|
Background: |
The protein encoded by this gene is a peripheral membrane protein localized to the trans-Golgi network. It is sensitive to brefeldin A. This encoded protein contains a GRIP domain which is thought to be used in targeting. Alternative splicing results in multiple transcript variants. |
|
Applications: |
ELISA, IHC |
|
Name of antibody: |
GCC2 |
|
Immunogen: |
Synthetic peptide of human GCC2 |
|
Full name: |
GRIP and coiled-coil domain containing 2 |
|
Synonyms: |
REN53; GCC185; RANBP2L4 |
|
SwissProt: |
Q8IWJ2 |
|
ELISA Recommended dilution: |
5000-10000 |
|
IHC positive control: |
Human liver cancer |
|
IHC Recommend dilution: |
50-300 |
購物車
幫助
021-54845833/15800441009
